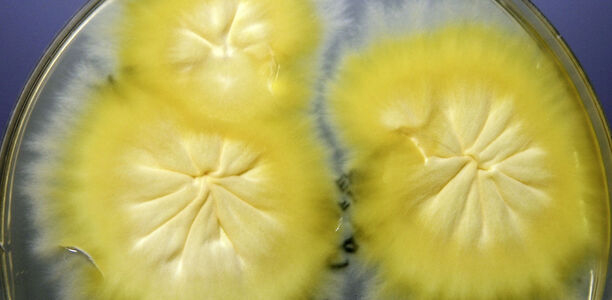
Bild zu Mykosen bei Kindern - Die Tinea von Fuß bis Kopf

Nagelpilz, Fußpilz, "Mattenpliz" aus Barber-Shops und Co: Mykosen wie die Tinea sind zwar lästig und stellen oft eine Herausforderung dar, lassen sich aber – auch in schweren Fällen – in der Kinderarztpraxis gut behandeln und heilen. Das Erregerspektrum ist breiter denn je.
Dieser Beitrag steht nur registrierten Benutzern mit Berufsverifizierung zur Verfügung. Jetzt anmelden.Mykosen bei Kindern
Die Tinea von Fuß bis Kopf
© H.-J. Tietz
© H.-J. Tietz
